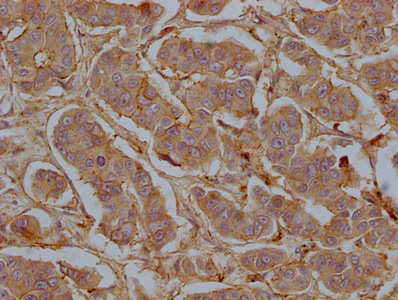

CD9 Monoclonal Antibody
-
中文名稱:CD9鼠單克隆抗體
-
貨號:CSB-MA004969A1m
-
規(guī)格:¥1320
-
圖片:
-
Western Blot
Positive WB detected in: U87 whole cell lysate, PC-3 whole cell lysate, 293 whole cell lysate, U251 whole cell lysate, A549 whole cell lysate, MG-63 whole cell lysate, MCF-7 whole cell lysate
All lanes CD9 antibody at 1:2000
Secondary
Goat polyclonal to mouse IgG at 1/50000 dilution
Predicted band size: 25 KDa
Observed band size: 25 KDa
Exposure time: 5min -
Western Blot
Positive WB detected in: A549 whole cell lysate at 20μg, 10μg, 5μg, 2.5μg whole cell lysate
All lanes CD9 antibody at 1:2000
Secondary
Goat polyclonal to mouse IgG at 1/50000 dilution
Predicted band size: 25 KDa
Observed band size: 25 KDa
Exposure time: 5min -
Western Blot
Positive WB detected in: 20μg A549 whole cell lysate
All lanes: CD9 antibody at 1:1000, 1:2000, 1:4000, 1:8000, 1:16000, 1:32000
Secondary
Goat polyclonal to mouse IgG at 1/50000 dilution
Predicted band size: 25 KDa
Observed band size: 25 KDa
Exposure time: 5min -
Western Blot
Positive WB detected in: 1.Exosomes extracted from plasma
2.Exosomes extracted from serum
3.Exosomes extracted from Hela cells
All lanes: CD9 antibody at 1:1000
Secondary
Goat polyclonal to mouse IgG at 1/50000 dilution
Predicted band size: 25 KDa
Observed band size: 25 KDa
Exposure time: 5min -
IHC image of CSB-MA004969A1m diluted at 1:50 and staining in paraffin-embedded human breast cancer tissue performed on a Leica BondTM system. After dewaxing and hydration, antigen retrieval was mediated by high pressure in a citrate buffer (pH 6.0). Section was blocked with 10% normal goat serum 30min at 37°C. Then primary antibody (1% BSA) was incubated at 4°C overnight. The primary is detected by a Goat anti-rabbit IgG labeled by HRP and visualized using 0.05% DAB.
-
IHC image of CSB-MA004969A1m diluted at 1:50 and staining in paraffin-embedded human kidney tissue performed on a Leica BondTM system. After dewaxing and hydration, antigen retrieval was mediated by high pressure in a citrate buffer (pH 6.0). Section was blocked with 10% normal goat serum 30min at 37°C. Then primary antibody (1% BSA) was incubated at 4°C overnight. The primary is detected by a Goat anti-rabbit IgG labeled by HRP and visualized using 0.05% DAB.
-
Immunofluorescence staining of Hela cells with CSB-MA004969A1m at 1:50, counter-stained with DAPI. The cells were fixed in 4% formaldehyde and blocked in 10% normal Goat Serum. The cells were then incubated with the antibody overnight at 4°C. Nuclear DNA was labeled in blue with DAPI. The secondary antibody was FITC-conjugated AffiniPure Goat Anti-Mouse IgG (H+L).
-
Immunofluorescence staining of HepG2 cells with CSB-MA004969A1m at 1:50, counter-stained with DAPI. The cells were fixed in 4% formaldehyde and blocked in 10% normal Goat Serum. The cells were then incubated with the antibody overnight at 4°C. Nuclear DNA was labeled in blue with DAPI. The secondary antibody was FITC-conjugated AffiniPure Goat Anti-Mouse IgG (H+L).
-
Overlay histogram showing A549 cells stained with CSB-MA004969A1m (red line) at 1:100. The cells were fixed in 4% formaldehyde and permeated by 0.2% TritonX-100. Then 10% normal goat serum was Incubated to block non-specific protein-protein interactions followed by the antibody (1μg/1*106cells) for 1 h at 4°C. The secondary antibody used was FITC-conjugated Goat Anti-Mouse IgG(H+L) at 1/100 dilution for 30min at 4°C. Isotype control antibody (green line) was mouse IgG1 (1μg/1*106cells) used under the same conditions. Acquisition of >10,000 events was performed.
-
Overlay histogram showing Jurkat cells stained with CSB-MA004969A1m (red line) at 1:100. The cells were fixed in 4% formaldehyde and permeated by 0.2% TritonX-100. Then 10% normal goat serum was Incubated to block non-specific protein-protein interactions followed by the antibody (1μg/1*106cells) for 1 h at 4°C. The secondary antibody used was FITC-conjugated Goat Anti-Mouse IgG(H+L) at 1/100 dilution for 30min at 4°C. Isotype control antibody (green line) was mouse IgG1(1μg/1*106cells) used under the same conditions. Acquisition of >10,000 events was performed.
-
Overlay histogram showing PC-3 cells stained with CSB-MA004969A1m (red line) at 1:100. The cells were fixed in 4% formaldehyde and permeated by 0.2% TritonX-100. Then 10% normal goat serum was Incubated to block non-specific protein-protein interactions followed by the antibody (1μg/1*106cells) for 1 h at 4°C. The secondary antibody used was FITC-conjugated Goat Anti-Mouse IgG(H+L) at 1/100 dilution for 30min at 4°C. Isotype control antibody (green line) was mouse IgG1 (1μg/1*106cells) used under the same conditions. Acquisition of >10,000 events was performed.
-
Overlay histogram showing U87 cells stained with CSB-MA004969A1m (red line) at 1:100. The cells were fixed in 4% formaldehyde and permeated by 0.2% TritonX-100. Then 10% normal goat serum was Incubated to block non-specific protein-protein interactions followed by the antibody (1μg/1*106cells) for 1 h at 4°C. The secondary antibody used was FITC-conjugated Goat Anti-Mouse IgG(H+L) at 1/100 dilution for 30min at 4°C. Isotype control antibody (green line) was mouse IgG1 (1μg/1*106cells) used under the same conditions. Acquisition of >10,000 events was performed.
-
-
其他:
產(chǎn)品詳情
-
產(chǎn)品描述:CD9單克隆抗體(CUSABIO貨號:CSB-MA004969A1m)是針對四次跨膜蛋白家族成員CD9靶點研發(fā)的高特異性科研工具。CD9作為細胞表面標志物,廣泛參與細胞黏附、遷移及胞外囊泡生成等生物學過程,其表達水平與腫瘤轉(zhuǎn)移、干細胞分化及免疫細胞活化等研究熱點密切相關(guān)。本產(chǎn)品采用雜交瘤技術(shù)制備,經(jīng)ELISA和Western Blot驗證可特異性識別人源CD9抗原,適用于體外實驗中對蛋白質(zhì)表達的定性檢測。其高親和力特性確保在免疫印跡中能清晰顯示約25kDa的靶蛋白條帶,為研究腫瘤微環(huán)境、外泌體功能調(diào)控、生殖細胞發(fā)育等領(lǐng)域的科研人員提供可靠工具。該抗體特別適用于探索癌細胞轉(zhuǎn)移機制、神經(jīng)突觸形成研究以及免疫細胞信號通路分析等前沿課題,為分子機制研究、藥物靶點篩選等基礎(chǔ)科研提供精準支持,相關(guān)領(lǐng)域研究者可通過該產(chǎn)品深入探究CD9在細胞膜動態(tài)調(diào)控中的分子作用。
-
產(chǎn)品名稱:Mouse anti-Homo sapiens (Human) CD9 Monoclonal antibody
-
Uniprot No.:
-
基因名:
-
別名:CD9; MIC3; TSPAN29; GIG2; CD9 antigen; 5H9 antigen; Cell growth-inhibiting gene 2 protein; Leukocyte antigen MIC3; Motility-related protein; MRP-1; Tetraspanin-29; Tspan-29; p24; CD antigen CD9
-
宿主:Mouse
-
反應種屬:Human
-
免疫原:Recombinant Human CD9 antigen protein (112-195AA)
-
免疫原種屬:Homo sapiens (Human)
-
標記方式:Non-conjugated
-
克隆類型:Monoclonal
-
抗體亞型:IgG1
-
純化方式:>95%, Protein G purified
-
克隆號:1E8H1
-
濃度:It differs from different batches. Please contact us to confirm it.
-
保存緩沖液:Preservative: 0.03% Proclin 300
Constituents: 50% Glycerol, 0.01M PBS, PH 7.4 -
產(chǎn)品提供形式:Liquid
-
應用范圍:ELISA, WB, IHC, IF, FC
-
推薦稀釋比:
Application Recommended Dilution WB WB:1:1000-1:32000 IHC 1:50-1:200 IF 1:50-1:200 FC 1:50-1:200 -
Protocols:
-
儲存條件:Upon receipt, store at -20°C or -80°C. Avoid repeated freeze.
-
貨期:Basically, we can dispatch the products out in 1-3 working days after receiving your orders. Delivery time maybe differs from different purchasing way or location, please kindly consult your local distributors for specific delivery time.
-
用途:For Research Use Only. Not for use in diagnostic or therapeutic procedures.
相關(guān)產(chǎn)品
靶點詳情
-
功能:Integral membrane protein associated with integrins, which regulates different processes, such as sperm-egg fusion, platelet activation and aggregation, and cell adhesion. Present at the cell surface of oocytes and plays a key role in sperm-egg fusion, possibly by organizing multiprotein complexes and the morphology of the membrane required for the fusion. In myoblasts, associates with CD81 and PTGFRN and inhibits myotube fusion during muscle regeneration. In macrophages, associates with CD81 and beta-1 and beta-2 integrins, and prevents macrophage fusion into multinucleated giant cells specialized in ingesting complement-opsonized large particles. Also prevents the fusion between mononuclear cell progenitors into osteoclasts in charge of bone resorption. Acts as a receptor for PSG17. Involved in platelet activation and aggregation. Regulates paranodal junction formation. Involved in cell adhesion, cell motility and tumor metastasis.
-
基因功能參考文獻:
- assays. Results from the present study demonstrated that CD9 was highly expressed in the highly metastatic Hepatocellular carcinoma (HCC)cells and promoted HCC cell migration. This protein may be a novel target for regulating the invasive phenotype in HCC. PMID: 29749468
- The species-specific traits in CD9 and CD81 distribution during sperm maturation were compared between mice and humans. A mutual position of CD9/CD81 is shown in human spermatozoa in the acrosomal cap, however in mice, CD9 and CD81 occupy a distinct area. PMID: 29671763
- CD9 expression predicts some clinical characteristics and indicates an unfavorable prognosis in acute lymphoblastic leukemia patients. PMID: 29286918
- CD9-CD81 blockage reduces exosome-mediated HIV-1 entry. PMID: 29429034
- Exosomal markers CD63 and CD9 are elevated in pancreatic tumor tissues. PMID: 28609367
- CD9 expression could be a biomarker for poor prognosis in invasive breast carcinoma PMID: 28178752
- CD9 stabilizes gp130 by blocking its ubiquitin-dependent lysosomal degradation to promote the IL6-gp130-bone marrow X-linked non-receptor tyrosine kinase-STAT3 signaling for maintaining GSC selfrenewal and tumorigenic capacity. PMID: 27740621
- CD9 was highly expressed on extravillous trophoblast (EVT) at the boundary region of EVT invasion and intravascular EVT. CD9 expression on Swan71 cells was reduced under hypoxic conditions, while its expression was increased by co-culture with HUVEC. CD9 could attenuate EVT invasion under the influence of an oxygen environment and maternal endothelial cells, proposing CD9 as a potential regulator of human placentation. PMID: 27780531
- As for 18Lin(-), CD34(-) HSCs are characterized by low expression of the tetraspanin CD9, which promotes homing, and high expression of the peptidase CD26, which inhibits homing. PMID: 28687990
- The findings suggest that, in contrast with previous models, the ligand-binding site of integrin alphaVbeta3, binds to the constant region (helices A and B) of the EC2 domain of CD9, CD81, and CD151 antigens. PMID: 27993971
- Data suggest that CD9 should be further evaluated as a target for glioblastoma treatment. PMID: 26573230
- Collectively, using tetraspanin CD9 in tandem with E-cadherin as a biomarker in renal cell carcinoma will help to not only distinguish between types, but also predict the metastatic potential of RCC. PMID: 26855131
- Data indicate that CD9 is implicated in BCC invasiveness and metastases by cellular mechanisms that involve specific CD9+ plasma membrane protrusions of BCCs. PMID: 25762645
- CD9-enriched microdomains negatively regulate LPS-induced receptor formation by preventing CD14 from accumulating into lipid rafts. [Review] PMID: 26378766
- Results indicate that CD9 downregulation promoted pancreatic cancer cell proliferation and migration through at least in part, enhancing the cell surface expression of EGFR. PMID: 25955689
- CD9 expression is upregulated and its expression is correlated with tumor stage and lymph node metastasis in esophageal squamous cell carcinoma patients PMID: 26045817
- Although the current findings did not prove any hypothesis, the indispensable role of CD9 in fertilization process was not excluded and the precise role of CD9 remains unexplained. [review] PMID: 25536312
- CD9 plays a role in the dysmegakaryopoiesis that occurs in primary myelofibrosis. PMID: 25840601
- High CD9 is associated with B acute lymphoblastic leukemia. PMID: 26320102
- These results suggested that the mechanism underlying CD9-induced suppression of cell proliferation may involve the inhibition of phosphorylation of EGFR and the activity of PI3K/Akt and MAPK/Erk signaling pathways PMID: 25760022
- OY-TES-1 downregulation in liver cancer cells inhibits cell proliferation by upregulating CD and downregulating NANOG. PMID: 25673160
- Low levels of CD9 coincidental with a novel nonsense mutation in glycoprotein Ibbeta in a patient with Bernard-Soulier syndrome. PMID: 26275786
- The cysteine residues involved in the formation of the disulfide bridges in CD9 EC2 were all essential for inhibiting multinucleated giant cell formation but a conserved glycine residue in the tetraspanin-defining 'CCG' motif was not. PMID: 25551757
- alteration in CD9 expression was sufficient to profoundly disrupt cellular actin arrangement and endogenous cell contraction by interfering with RhoA signaling. PMID: 25184334
- The mechanism responsible for this negative regulation exerted by CD9 on LFA-1 adhesion does not involve changes in the affinity state of this integrin but seems to be related to alterations in its state of aggregation. PMID: 26003300
- The results demonstrate that hypoxia regulates CD9 expression and CD9-mediated keratinocyte migration via the p38/MAPK pathway. PMID: 25200404
- Report shows that breast cancer cells contain a nuclear CD9 pool and that the abrogation of CD9 expression results in multipolar mitoses and polynucleation. PMID: 25103498
- this study indicated that sialylation involved in the development of MDR of AML cells probably through ST3GAL5 or ST8SIA4 regulating the activity of PI3K/Akt signaling and the expression of P-gp and MRP1. PMID: 24531716
- switch from alphavbeta5 to alphavbeta6 integrin plays a key role in CD9-regulated cell migration and MMP-9 activation in keratinocytes PMID: 25265322
- High expression of CD9 was statistically associated with older patients PMID: 24553302
- CD9 and CD63 tetraspanins block HIV-1-induced cell-cell fusion at the transition from hemifusion to pore opening. PMID: 24608085
- Loss of CD9 expression is associated with enhancement of invasive potential of malignant mesothelioma. PMID: 24466195
- CD9 and CD151 support integrin-mediated signaling at the immunological synapse. PMID: 24723389
- Introduction of CD9 expression in Raji cells resulted in significantly increased cell proliferation and HDAC activity compared to mock transfected Raji cells. PMID: 24747564
- Heparin-binding epidermal growth factor and CD9 are likely implicated in processes that are highly relevant for MS lesion formation PMID: 24038577
- this study points to EGFR as a key mediator between CD9-mediated pro-MMP-9 release and cellular invasion of HT1080 cells. PMID: 24246676
- The second extracellular loop of CD9 was responsible for the upregulation of MMP-9 production. PMID: 23840773
- This is the first study of the expression and prognostic potential of the tetraspanins in oral dysplasia. PMID: 24201754
- Low CD9 expression is associated with malignant mesothelioma. PMID: 23128478
- Both CD9/CD81-silenced cells and CD151-silenced cells showed delayed alpha3beta1-dependent cell spreading on laminin-332. PMID: 23613949
- Data indicate that CD9 acts as scaffold and assembles a ternary JAM-A-CD9-alphavbeta3 integrin complex from which JAM-A is released upon bFGF stimulation. PMID: 23389628
- these data suggest that CD9 is a novel marker for a human germinal center-B cell subset that is committed to plasma cell lineage. PMID: 23291167
- CD9 overexpression was confirmed in osteotropic cells. CD9 was significantly overexpressed in bone metastases versus primary tumors and visceral metastatic lesions. PMID: 23225418
- tetraspanin CD9 modulates molecular organization of integrins in lymphatic endothelial cells, thereby supporting several functions required for lymphangiogenesis PMID: 23223239
- Low CD9 expression is associated with gallbladder neoplasms PMID: 22613496
- identifies human male germ cells with capability of long-term survival and cell turnover in the xenogeneic testis environment PMID: 22592495
- Knockdown of CD9 by siRNA and blockage of CD9 activity by ALB6 in ovarian cancer cells demonstrated that constitutive activation of NF-kappaB is CD9 dependent and that CD9 is involved in anti-apoptosis PMID: 22095071
- CD9 increases GCM1 expression via the cAMP/PKA signaling pathway, resulting in the increase in ERVWE1 expression. PMID: 19692500
- The absence or down-regulation of CD9 expression and point mutation may play a considerable role in the pathway of the malignant transformation in the BEAS-2B cells induced by mineral powder. PMID: 17997888
- CD9 associates with ADAM17 and, through this interaction, negatively regulates the sheddase activity of ADAM17. PMID: 21365281
顯示更多
收起更多
-
亞細胞定位:Cell membrane; Multi-pass membrane protein. Membrane; Multi-pass membrane protein. Secreted, extracellular exosome.
-
蛋白家族:Tetraspanin (TM4SF) family
-
組織特異性:Detected in platelets (at protein level). Expressed by a variety of hematopoietic and epithelial cells.
-
數(shù)據(jù)庫鏈接:
Most popular with customers
-
-
YWHAB Recombinant Monoclonal Antibody
Applications: ELISA, WB, IHC, IF, FC
Species Reactivity: Human, Mouse, Rat
-
Phospho-YAP1 (S127) Recombinant Monoclonal Antibody
Applications: ELISA, WB, IHC
Species Reactivity: Human
-
-
-
-
-